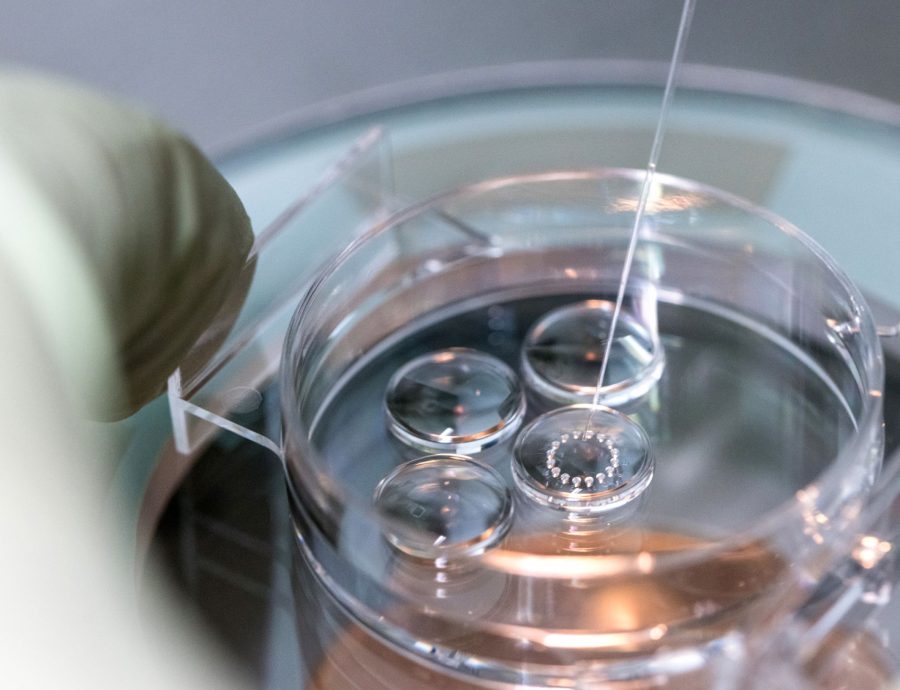

- Giới thiệu
- Dịch vụ
- Quy trình thăm khám và điều trị vô sinh tại Trung tâm IVF Hồng Ngọc
- Thụ tinh trong ống nghiệm (IVF) và Tiêm tinh trùng vào bào tương noãn (ICSI)
- Bơm tinh trùng vào buồng tử cung IUI
- Mini IVF – Chu kỳ kích trứng tối thiểu chỉ từ 30 Triệu
- IVF Standard – Liệu trình IVF trọn gói 60 triệu
- Chẩn đoán và sàng lọc di truyền tiền làm tổ (PGD/ PGS)
- Phẫu thuật lấy tinh trùng từ mào tinh (PESA, MESA)
- Ứng dụng công nghệ Timelapse trong nuôi cấy phôi
- Lựa chọn tinh trùng sống bằng Laser (LAISS)
- Lựa chọn tinh trùng bằng phương pháp từ trường (MACS)
- Phương pháp lọc rửa tinh trùng bằng dòng vi dịch (MFSS)
- PIEZO ICSI – Công nghệ tạo phôi tiên tiến, nâng cao tỷ lệ thành công trong IVF
- Kiến thức
- Những em bé của chúng tôi
- Tin tức
- Liên hệ
-
-

 English
English